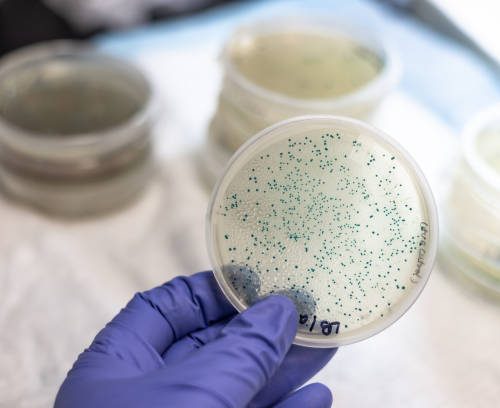
Microbial Whole Genome Sequencing (Bacteria < 7MB)

Mostrando los 2 resultados
-
OFERTA 
Metagenomics 16S rRNA – gen completo
El precio original era: $ 89.99.$ 59.99El precio actual es: $ 59.99. -
OFERTA
Microbial Whole Genome Sequencing (Bacteria < 7MB)
El precio original era: $ 79.99.$ 49.99El precio actual es: $ 49.99.
